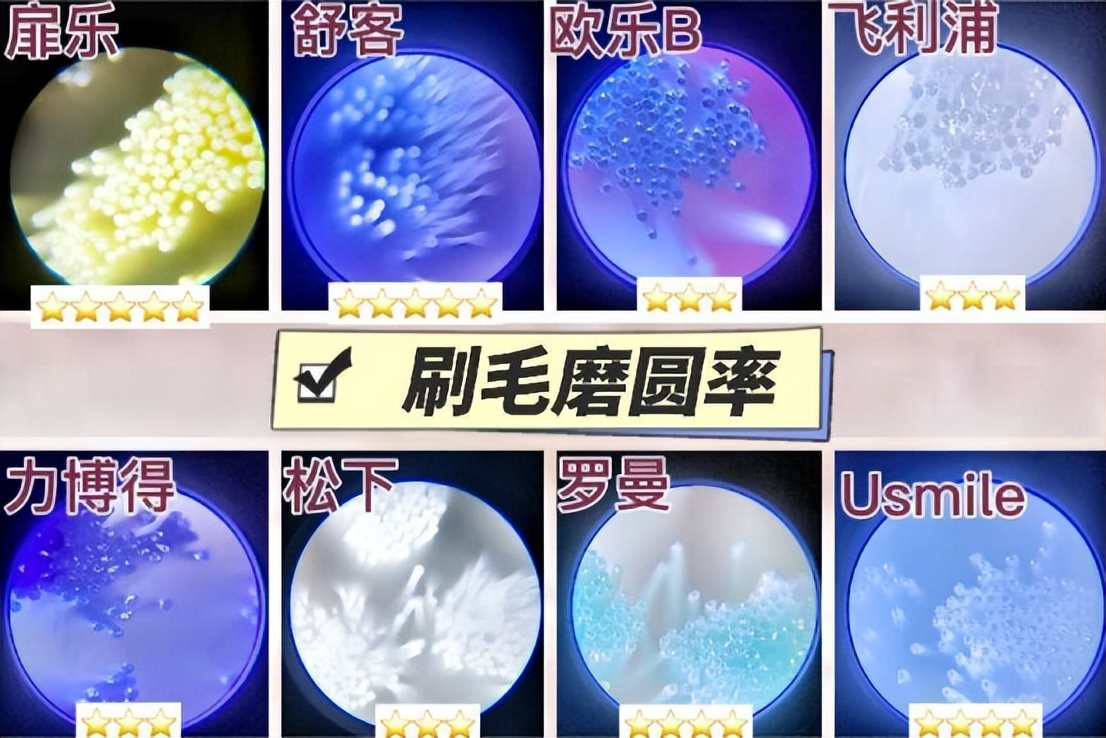
儿童电动牙刷品牌前十名评测,评测儿童电动牙刷排名前十名

作为母婴健康博主,我非常喜爱对各类母婴新产品做专项测评,例如安全座椅、孩子水瓶、纸尿裤等,但是从来没有测评儿童电动牙刷,因为我深知测评这个类目除了需要对母婴产品了解还需要丰富的口腔护理专业知识。
但是最近实在是问到关于儿童电动牙刷怎么选的朋友越来越多,于是我就花了1个多月专研整理了各种几万字的口腔护理干货,然后决定今天一边测评一边给大家讲解下细节!为此,我全新购入儿童电动牙刷排名前十的热门机型,为大家安排了本期儿童电动牙刷测评。

我希望能够结合牙医的专业度和母婴博主的经验,通过客观严谨的测评数据,为家长梳理出科学专业的儿童电动牙刷的选购技巧。
阅读指引
1.儿童电动牙刷常见问题科普
1-1 为什么牙医不会轻易为孩子推荐儿童电动牙刷?
1-2 电动牙刷选购常见营销陷阱
2.儿童电动牙刷排名前十热门机型测评
1-1 清洁力对比
1-2 护牙力对比
1-3 刷头选择对比
1-4 刷毛综合细节对比
1-5 噪音对比
1-6 售后对比
3.儿童电动牙刷机型推荐
一、 儿童电动牙刷常见问题科普
我归纳了家长提问比较多的问题,深度咨询了孩子的牙医以及查了一圈行业内的口腔护理和电动牙刷电子构造的相关资料后,对几个典型的问题做了回答。对儿童电动牙刷已经做过功课的家长可以简单阅读来查缺补漏,新手家长最好反复学习。
1.为什么牙医不会轻易为孩子推荐儿童电动牙刷?
孩子的牙医解释道,其实身边的很多牙医都是推荐儿童使用电动牙刷的,只是担心孩子的口腔比较稚嫩,并且会因为选购踩坑和使用方法错误的原因伤害到口腔,所以推荐比较谨慎。
我在儿童电动牙刷电商论坛上找到了家长对于儿童牙刷的负面评价如下,可以看出,牙刷容易伤牙、刷毛品质差、用料敷衍、清洁力低等现象是手动牙刷和电动牙刷都会存在的问题,因此我们无需过于焦虑,只要选购谨慎这些问题就可以完全规避。

原因一 :孩子在成长阶段的口腔发育普遍很快, 一旦儿童电动牙刷的震频偏窄或者刷头选择很少,就无法适应不同的孩子处在不同发育阶段的口腔需求 ,伤牙风险极高。很多品牌厂商为了节省研发和调教时间,只设计两个模式搭配一种刷头的简单组合应对三至十五岁的儿童,这样的产品怎么能适合孩子?所以牙医不是不推荐儿童使用电动牙刷,而是担心电动牙刷震频窄、刷头选择少,容易造成伤牙或者刷不干净的问题,影响孩子的口腔发育。
原因二 :无论是三岁的幼龄儿童还是十五岁的青少年,口腔都要比成年人稚嫩脆弱很多,一旦受到外界的过度刺激就会有伤牙风险。市面上有很多电动牙刷品牌为了追求强力清洁,震频过高、震感剧烈,如果误选了震频过高的儿童电动牙刷,非常容易伤牙。

原因三 :孩子刷牙往往无法把控力度,学习成本很高,大部分孩子的刷牙方法都是错误的。一旦误选了容错率太低的儿童电动牙刷,就会产生伤牙的后果。 容错率高的电动牙刷能够实现孩子随意刷牙也不会伤牙的保护目的,这类产品牙医是非常推荐的 。
原因四: 过于 低价的儿童电动牙刷 成本压的很低,特别是百元以内的产品, 普遍使用空心杯马达、磨圆率低的刷毛、粗糙的结构设计, 孩子一旦开始刷牙就会磨损牙齿,加大伤牙风险。牙医建议,选择儿童电动牙刷一定规避低价产品。

原因五 :网红品牌和跨界品牌为了维持产品的销量和热度,营销成本非常高,家长往往会一不小心就被*脑洗**跟风购买, 实际上这种非实力技术品牌完全没有口腔护理经验和技术调教经验积累,无法对儿童电动牙刷的震频范围、摆幅角度、刷毛磨圆率进行严格的测试优化, 很难兼容不同年龄阶段儿童口腔发育情况,牙医不敢轻易推荐。
2.电动牙刷选购常见营销陷阱
前文讲过,疯狂营销的网红品牌和跨界品牌会设计很多营销陷阱,这些陷阱往往需要口腔行业从业者才能判断。综合孩子爸爸的建议,我归纳了七个儿童电动牙刷常见营销陷阱,家长选购的时候注意判断。
陷阱一 :很多品牌宣称自己对儿童电动牙刷进行了分龄,但其实完全没有做到专业细分。儿童乳牙和恒牙各个发育时期对电动牙刷的要求都不同,所以口腔的发育不能粗暴的划分为大小儿童。宣称三岁至十五岁都可以使用,但实际上只配备了单一刷头和两种模式的产品完全忽略了对震频、摆幅和刷毛进行全面调教与优化,无法兼容孩子快速的口腔变化,只有震频跨度大且刷头选择多的儿童电动牙刷才能做到让孩子的每一种口腔状态都能调节到合适的模式。

陷阱二 :品牌为了增加营销卖点,会推出各种看似高级实则无用的噱头来吸引家长购买,典型的陷阱有抑菌刷毛、含氟刷毛等功能性刷毛设计。我们为孩子选择儿童电动牙刷,需要重点关注的是刷毛植毛率、植毛量、磨圆率、形状设计以及对牙齿的包裹性这些核心参数,附加功能几乎没有什么作用。

陷阱三 :不少儿童电动牙刷打着高性价比的旗号,售卖低价劣质产品。高性价比是建立在儿童电动牙刷品质和专业性的基础上来全面评估,而不能只看价格。低价产品的马达劣质,刷毛粗糙,伤牙风险非常高,一定不要给孩子使用。
陷阱四 :有时候,品牌的售后服务会玩文字陷阱,宣称产品可以七天无理由退货,实则不支持试用,一旦拆封就不退货。购买儿童电动牙刷之前,一定要详细询问客服,是否支持七天试用,否则家长只能吃哑巴亏。
陷阱五 :专家实验表明,U型牙刷的刷毛间隙过大且硅胶刷毛设计无法深入牙缝进行深度清洁,清洁能力还不如儿童手动牙刷,容易变形的刷毛还会刺激牙齿牙龈,绝对是智商税。

陷阱六 :打着护龈护牙旗号的儿童电动牙刷在市面上非常普遍,但能够做到专业精细调教的品牌实则少之又少。声称自己护龈,其实产品的设计完全没有考虑到孩子不同的发育阶段的兼容匹配度,也没有做到高容错率,甚至连马达、刷头这些核心参数都未经过专业的调教与优化,怎么能做到护龈?

陷阱七 :不少大牌直接用成人电动牙刷的机身换一个外观颜色替代儿童电动牙刷,震频、动力强度、力度跨度、摆幅、刷毛完全未经修改,孩子的口腔要比成人脆弱很多,使用这种未经调整的电动牙刷务必会影响口腔的发育。

-------------------------------------------------------------------------------
二、儿童电动牙刷排名前十热门机型测评
知识科普中我提到过 网红和跨界品牌更多是通过打造各种概念噱头然后堆砌表面参数,实则忽略内部核心零部件结构和性能的调教优化 ,导致儿童电动牙刷的实际性能存疑,所以我拒绝了很多博主单纯对比表面参数的测评方式 ,把侧重点放在了实际清洁效果和使用舒适度以及兼容适配性上 。为了保证测评的真实客观,我在牙医的指导下进行了此次儿童电动牙刷测评,并且请女儿对每支电动牙刷进行了为期两周的试用。下面是参与测评的电动牙刷品牌与型号。

儿童电动牙测评一:清洁力对比
清洁力强的电动牙刷可以深入死角盲区,全面清除牙菌斑,有效预防孩子蛀牙的发生,所以儿童电动牙刷排名前十热门机型测评的第一关就是考核清洁力。
电动牙刷的 清洁力不单单与震频参数相关,需要综合震动摆幅的均衡性、持续衰减性,刷头尺寸、形状、植毛设计是否能够深入死角同时对牙齿的包裹性良好等核心细节判断 ,只有能够对电动牙刷内部结构做到精细调校测试的品牌才能做到实现高清洁度的同时不伤牙。
我把巧克力融化后涂抹在牙齿模型上,打开不同电动牙刷的清洁档位,对牙齿模型进行两分钟的清洁。

★★★★★/欧乐B、飞利浦、扉乐
欧乐B、飞利浦、扉乐的清洁力强大,整体清洁完成度非常高,牙缝和死角也能清洁干净,但是使用感受差异巨大。欧乐B利用强大的旋转摩擦力来清洁牙齿,飞利浦利用剧烈的震动和偏硬刷毛来完成全面清洁,二者都会对孩子的牙齿产生过重磨损。
扉乐则是应用了独创的核定震频技术,摆幅稳定均匀,综合技术作用下口腔不仅能得到深度清洁,孩子使用感受也更为舒适。
★★★★/力博得、松下、Usmile
力博得、松下、Usmile的清洁力也还可以的,牙龈线有少量的残留,延长刷牙时间可以达到彻底清洁。松下的刷头过大难以深入死角,力博得和usmile则是动力不够均衡从而影响了清洁力表现。
★★★/罗曼、舒客
罗曼和舒客的清洁力较弱,牙缝和牙龈线的残留非常明显,但是也能明显感觉这两款产品的定位是幼龄儿童,震动和刷毛表现还是比较舒服的,可能是打算弱化清洁来实现高效护牙。
儿童电动牙测评二:护牙力对比
儿童电动牙刷排名前十热门机型测评的第二关是重点关注的护牙力,也是我咨询牙医的时候他们非常关注的点。孩子的牙龈要比成年人稚嫩很多,不同成长时期的口腔环境发育变化迅速,因此对儿童电动牙刷的护牙力的要求也有明显变化。
儿童电动牙刷的 护牙力不仅仅跟刷毛柔软度相关,核心取决于马达震动的均衡稳定性、刷毛材质、磨圆、柔软度、刷头尺寸等众多细节数据,需要全方位的考究 。
我用用不同的电动牙刷的清洁档位对湿纸巾进行三十秒的清洁,观察清洁完成后纸巾的磨损程度。

★★★★★/扉乐、舒客
扉乐和舒客的护牙力很高,湿纸巾经过三十秒的清洁几乎没有磨损,只有表面的牙刷刷过的痕迹。扉乐的出众表现主要得益于品牌研发的八大护牙黑科技,能够兼顾高清洁力和高护牙力;舒客刷毛质感好且柔软,震感摆幅微弱,所以护牙力好,但牺牲了一定清洁力。
★★★★/罗曼
罗曼的护牙力良好,儿童电动牙刷的震动相对温和,刷头非常小巧,刷毛适中偏软,可惜磨圆率较低,影响护牙力发挥,整体不错了。
★★★/力博得、Usmile
相比罗曼,力博得和Usmile的护牙力急需提升,这两支电动牙刷的刷毛偏硬,磨圆率也不尽人意,同时力博得不是非常稳定的震动频率也降低了护牙力表现。
★★/欧乐B、飞利浦、松下
欧乐B、飞利浦、松下的护牙力非常低,欧乐B和飞利浦的刷毛偏硬、震感剧烈、磨圆率低,松下的动力调教得不理想,很容易对孩子的牙齿造成磨损,伤牙风险极高,十二岁以上并且牙龈耐受高的青少年可以试试。
儿童电动牙测评三:刷头选择对比
从文章开始我就反复强调,孩子的口腔处于动态发育变化中,不同年龄的孩子在发育过程中会经历不同的口腔阶段,特别是乳牙的萌生到换牙期和恒牙的发育到稳固期,发育速度很快,这就需要儿童电动牙刷 拥有丰富的刷头选择,同时搭配跨度较大的震频调节 来适应不同阶段的口腔情况。因此儿童电动牙刷排名前十热门机型测评,我对刷头的选择也进行了评估。

4种/扉乐
扉乐配备了四种刷头,不同选择针对刷头大小尺寸、刷毛硬度、裁切形状细节、植毛率等都有较大差异设计,能够满足孩子牙齿生长发育阶段的全年龄段覆盖使用,同时扉乐的震频跨度大、力度变化明显,儿童电动牙刷的兼容匹配度很高。
2种/Usmile、力博得、松下
力博得、Usmile和松下有两种刷头可以选择,但是力博得和Usmile的两种刷头主要调整了尺寸和形状来适应大小儿童,植毛率和软硬等刷毛细节变化不明显;松下的两种刷头只有一种可以刷牙,另一种则是清洁牙缝的刷头,对于真正刷牙清洁意义不大,到时可以用户日常的牙缝清洁护理。
1种 / 罗曼、欧乐B、飞利浦、舒客
罗曼、欧乐B、飞利浦、舒客只配备了一种刷头,年龄的匹配度非常低,要么只适合幼龄儿童,要么只适合大一点的孩子,不太能适应所有年龄段和牙齿状态的孩子使用。
儿童电动牙测评四:刷毛细节对比
刷毛的细节影响着电动牙刷的舒适度和清洁效果,需要综合刷毛软硬、磨圆率、形状设计、包裹性、植毛率等细节数据进行整体评估,儿童电动牙刷的刷毛需要根据不同发育阶段来进行调整选择,所以儿童电动牙刷排名前十热门机型测评,我会详细结合刷毛软硬和磨圆率的对比来提供选购指导。
刷毛软硬度
孩子的口腔是一直在发育变化的,千万不要盲目的一直使用过软或过硬的刷毛。 幼龄儿童适合偏软刷毛,刷牙目的以呵护为主,清洁为辅,八岁以上的普通儿童可以选择软硬适中偏软刷毛,保证清洁力的同时兼顾对牙齿和额牙龈的呵护 。
我把不同的电动牙刷刷毛按在桌子上,观察刷毛弯曲的程度,刷毛弯曲越大,证明刷毛越软。

偏硬/飞利浦、欧乐B、Usmile
飞利浦、欧乐B、Usmile的刷毛对于儿童来说实在是偏硬了,如果调整柔软一点可能综合体验会更好。
偏软/扉乐、舒客、松下
扉乐匹配了四种刷头,我全部都能测评了一遍。扉乐专为幼儿设计的2款刷头质地偏软,能够更好的呵护幼小的牙龈,而专为八岁以上儿童设计的刷头适中偏软,可以实现清洁度和护牙度的兼容,刷毛的软硬设计调整非常科学。
舒客、松下的刷毛偏软,幼儿用起来会比较安心,但是八岁以上的孩子可能较难达到清洁效果。
适中偏软/力博得、罗曼、扉乐
力博得、罗曼的刷毛软硬适中偏软,幼龄儿童使用可能会对口腔产生负荷,有伤牙的风险,相对来说更加适合年纪较大的孩子使用;扉乐针对的大童刷头质地适中偏软前面说过了。
儿童电动牙测评五:刷毛磨圆率
电动牙刷的磨圆率越高,越能保护孩子稚嫩的口腔, 成人电动牙刷的磨圆率要求高于60%,而儿童电动牙刷的磨圆率至少要高于80%才算合格。 高磨圆率需要付出很多的时间成本和严苛的多重工序反复打磨测试,磨圆率越高体现品牌研制流程也越专业精细,所以儿童电动牙刷排名前十热门机型测评,需要对比磨圆率这道无法肉眼观察得出结论的环节。
我把电动牙的刷毛在高倍显微镜下放大一百倍,拍摄下照片,可以清晰的看到磨圆率对比。
★★★★★/扉乐、舒客
扉乐和舒客的磨圆率非常高,刷毛尖部光滑有弧度,打磨精细度好,对牙齿和牙龈的保护程度比较高。另外,扉乐的刷头较小,植毛率适中,裁切形状对牙齿有很好的包裹性,而舒克美中不足是刷头偏大难以深入死角清洁,但植毛率和材质也表现得很不错的。
★★★★/罗曼、Usmile
罗曼和Usmile的刷毛磨圆率表现普通,对刷牙舒适度稍有影响。
★★★/欧乐B、飞利浦、松下、力博得
欧乐B、飞利浦、松下、力博得的磨圆率过低,刷毛尖部过于锐利,有明显的裁切痕迹,可以看出打磨不够精细,有可能对牙釉质和牙龈造成较严重磨损,建议十二岁以上的孩子使用。
儿童电动牙测评六:噪音对比
使用体验方面,孩子使用电动牙刷的时候,噪音太大会让刷牙的过程变得格外痛苦,久而久之孩子会抗拒刷牙,产生抵触心理。
品质方面,电动牙刷噪音大是内部结构不稳定并且密封性差的结果,所以我希望能够通过儿童电动牙刷排名前十热门机型测评对比选出噪音较小的产品。
我在同样安静的环境下记录不同电动牙刷运行时的声音大小,电动牙刷运行时距离分贝仪两厘米处。

★★★★★/扉乐、飞利浦、罗曼
这三款的噪音非常微弱,平均都在60分贝左右,可见电动牙刷的内部结构非常稳定。
★★★★/舒客、力博得
舒客、力博得噪音一般,不大不小,还在可以接受的范围,但是幼龄儿童不一定能完全接受。
★★★/欧乐B、松下、Usmile
欧乐B和松下的噪音明显偏大,分贝已经超过了七十,对声音敏感的成人都可能会觉得很不舒服,更不用说孩子了。
儿童电动牙测评七:售后对比
为女儿选购电动牙刷的过程中,我和孩子爸爸非常关注售后,所以儿童电动牙刷排名前十热门机型测评的最后一关,我重点收集资料对比了质保年限、是否支持试用和刷头替换成本这三个方面,因为孩子使用的过程中可能会出刷牙方式不正确导致刷毛炸毛频繁需要更换、因此刷头替换成本是很多家长容易忽略的但是我这边一定要重点提醒的一个点!

-------------------------------------------------------------------------------
三、儿童电动牙刷机型推荐
通过以上儿童电动牙刷排名前十热门机型测评,我综合女儿的试用感受筛选出三款综合实力比较强的机型,家长可以根据孩子的情况来量身选择。
专业实力品牌可选:扉乐VIIV

扉乐是国内唯一专业不伤牙的技术品牌,拥有多年口腔护理和技术调教经验,他家儿童电动牙刷主打“高容错+不伤牙”, 独家研发的八大不伤牙黑科技不仅能够实现超高清洁度的同时每次降低90%损伤,而且就算是孩子刷牙方法错误的极端场景下也不会伤牙 ,难怪得到众多牙医推荐!
除了超高的安全性,让我安心给孩子选的另一个重要原因则是扉乐的全链式六型分段护理, 3种模式+4种刷头是业内跨度最大的一款儿童牙刷,可以真正适配3-15岁孩子,这种严谨的分段护理完全区别于简单的两段式分龄法 ,目前业内只有扉乐做得到。另外,千元水准的马达和刷头加上7天试用+送5年刷头的良心售后,长远来说性价比真的非常高。
高颜值*党**可选: Usmile Q3S

Usmile是近年知名度很高的新晋网红品牌,在天猫上的销量一直很可观。品牌对于营销很舍得投入,请了了不少当红明星和博主进行代言宣传。Usmile的儿童电动牙刷外观设计的非常可爱,比较受孩子欢迎。
电动牙刷的清洁能力还可以,但是刷头太宽,容易存在清洁盲区,而且刷毛偏硬震感过于强以及机身过于重(超过130g),不太适合幼龄儿童,建议十岁以上的孩子可能比较合适。
十二岁以上可选:飞利浦HX6322

国际大品牌飞利浦的知名度不用我多说,电动牙刷产品线非常齐全,儿童产品是其中一个支线。这支电动牙刷的刷头比较小巧,可以在口腔内灵活移动,清洁力非常强大,几乎不存在清洁盲区,但是震感很强,刷毛偏硬,磨圆率不高,只适合十二岁以上且牙齿耐受度高的孩子使用。
通过儿童电动牙刷排名前十热门机型测评,各位家长可以发现,儿童电动牙刷的清洁力和安全性是手动牙刷远远做不到的,只要避开品牌的营销陷阱,教会孩子正确使用电动牙刷的方法,就能维护口腔健康,对孩子的发育起到正面作用,最后希望本期儿童电动牙刷测评为你提供有效的选购建议。